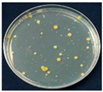
Polymers 14 01794 i002
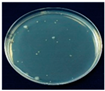
Polymers 14 01794 i003
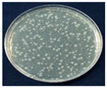
Polymers 14 01794 i007
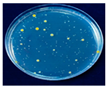
Polymers 14 01794 i008
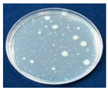
Polymers 14 01794 i009

A Low-Density Polyethylene (LDPE)/Macca Carbon Advanced Composite Film with Functional Properties for Packaging Materials
Abstract
:1. Introduction
2. Materials and Experimental Method
2.1. Materials
2.2. Characterization
2.2.1. Fundamental Characterization of MC Powder
2.2.2. Morphological Characterizations
2.2.3. Thermal Properties
2.2.4. Mechanical Properties
2.2.5. FIR Irradiation Characteristics
2.2.6. Barrier Properties
2.2.7. Light Transmission and Opacity Properties
2.2.8. Antimicrobial Activities
2.2.9. Storage Tests
3. Results and Discussion
3.1. Fundamental Characteristics of MC Powder
3.2. LDPE/MC Composite Film Fabrication
3.3. Thermal Properties
3.4. Mechanical Properties
3.5. FIR Emission
3.6. Barrier Properties
3.7. Light Transmission and Opacity Properties
3.8. Antimicrobial Activities
3.9. Storage Tests
4. Conclusions
Author Contributions
Funding
Institutional Review Board Statement
Informed Consent Statement
Data Availability Statement
Acknowledgments
Conflicts of Interest
References
- Appendini, P.; Hotchkiss, J.H. Review of antimicrobial food packaging. Innov. Food Sci. Emerg. Technol. 2002, 3, 113–126. [Google Scholar] [CrossRef]
- Sharma, R.; Jafari, S.M.; Sharma, S. Antimicrobial bio-nanocomposites and their potential applications in food packaging. Food Control 2020, 112, 107086. [Google Scholar] [CrossRef]
- Sung, S.-Y.; Sin, L.T.; Tee, T.-T.; Bee, S.-T.; Rahmat, A.R.; Rahman, W.A.W.A.; Tan, A.-C.; Vikhraman, M. Antimicrobial agents for food packaging applications. Trends Food Sci. Technol. 2013, 33, 110–123. [Google Scholar] [CrossRef]
- Joerger, R.D. Antimicrobial films for food applications: A quantitative analysis of their effectiveness. Packag. Technol. Sci. 2007, 20, 231–273. [Google Scholar] [CrossRef]
- Malhotra, B.; Keshwani, A.; Kharkwal, H. Antimicrobial food packaging: Potential and pitfalls. Front. Microbiol. 2015, 6, 611. [Google Scholar] [CrossRef] [PubMed] [Green Version]
- Huang, T.; Qian, Y.; Wei, J.; Zhou, C. Polymeric Antimicrobial Food Packaging and Its Applications. Polymers 2019, 11, 560. [Google Scholar] [CrossRef] [PubMed] [Green Version]
- Vartiainen, J.; Skytta, E.; Ahvenainen-Rantala, R.; Enqvist, J. Antimicrobial and Barrier Properties of LDPE Films Containing Imazalil and EDTA. J. Plast. Film Sheeting 2003, 19, 249–261. [Google Scholar] [CrossRef]
- Emamifar, A. Applications of antimicrobial polymer nanocomposite in food packaging. In Advances in Nanocomposite Technology; Hashim, A., Ed.; InTech: Vienna, Austria, 2011; pp. 299–318. [Google Scholar]
- Zhang, L.; Jiang, Y.; Ding, Y.; Povey, M.; York, D. Investigation into the antibacterial behaviour of suspensions of ZnO nanoparticles (ZnO nanofluids). J. Nanopart. Res. 2007, 9, 479–489. [Google Scholar] [CrossRef]
- Talegaonkar, S.; Sharma, H.; Pandey, S.; Mishra, P.K.; Wimmer, R. Bionanocomposite: Smart biodegradable packaging material for food preservation. In Food Packaging; Grumezescu, A.M., Ed.; Academic Press: London, UK, 2017; pp. 79–110. [Google Scholar]
- Yam, K.L. Design of modified atmosphere packaging for fresh produce. In Active Food Packaging; Rooney, M.L., Ed.; Chapman and Hall: Glasgow, Scotland, 1995; pp. 55–73. [Google Scholar]
- Xiong, Y.; Huang, S.; Wang, W.; Liu, X.; Li, H. Properties and Applications of High Emissivity Composite Films Based on Far-Infrared Ceramic Powder. Materials 2017, 10, 1370. [Google Scholar] [CrossRef] [PubMed] [Green Version]
- Teraoka, F.; Hamada, Y.; Takahashi, J. Bamboo charcoal inhibits growth of HeLa cells in vitro. Dent. Mater. J. 2004, 23, 633–637. [Google Scholar] [CrossRef] [Green Version]
- Ishibashi, J.; Yamashita, K.; Ishikawa, T.; Hosokawa, H.; Sumida, K.; Nagayama, M.; Kitamura, S. The effects inhibiting the proliferation of cancer cells by far-infrared radiation (FIR) are controlled by the basal expression level of heat shock protein (HSP) 70A. Med. Oncol. 2008, 25, 229–237. [Google Scholar] [CrossRef] [PubMed] [Green Version]
- Ketsuk, P.; Lim, M.; Baek, S.H.; Jung, J.; Kim, D.; Malegowd, R.G.; Seo, J.; Khan, S.B. LDPE composite films incorporating ceramic powder emitting far-infrared radiation for advanced food-packaging applications. J. App. Polym. Sci. 2016, 133, 43102. [Google Scholar] [CrossRef]
- Vatansever, F.; Hamblin, M.R. Far infrared radiation (FIR): Its biological effects and medical applications: Ferne Infrarotstrahlung: Biologische Effekte und medizinische Anwendungen. Photonics Lasers Med. 2012, 1, 255–266. [Google Scholar] [CrossRef] [PubMed] [Green Version]
- Inoué, S.; Kabaya, M. Biological activities caused by far-infrared radiation. Int. J. Biometeorol. 1989, 33, 145–150. [Google Scholar] [CrossRef] [PubMed]
- Wang, F.; Liang, J.; Tang, Q.; Li, L.; Han, L. Preparation and Far Infrared Emission Properties of Natural Sepiolite Nanofibers. J. Nanosci. Nanotechnol. 2010, 10, 2017–2022. [Google Scholar] [CrossRef] [PubMed]
- Chung, J.; Lee, S. Development of nanofibrous membranes with far-infrared radiation and their antimicrobial properties. Fibers Polym. 2014, 15, 1153–1159. [Google Scholar] [CrossRef]
- Nitayaphat, W.; Jiratumnukul, N.; Charuchinda, S.; Kittinaovarat, S. Mechanical properties of chitosan/bamboo charcoal composite films made with normal and surface oxidized charcoal. Carbohydr. Polym. 2009, 78, 444–448. [Google Scholar] [CrossRef]
- Tangvijitsakul, P. The Investigation on applications of Macca Charcoal. Master’s Thesis, Polymer Science and Technology, Department of Chemistry, Faculty of Science, Mahidol University, Salaya, Thailand, 2010. [Google Scholar]
- JIS Z 2801; Antimicrobial Products—Test for Antimicrobial Activity and Efficacy. Japanese Industrial Standard Association: Tokyo, Japan, 2000. Available online: https://airmidhealthgroup.com/jis-z-2801.html (accessed on 1 April 2022).
- Lee, K.T. Quality and safety aspects of meat products as affected by various physical manipulations of packaging materials. Meat Sci. 2010, 86, 138–150. [Google Scholar] [CrossRef] [PubMed]
- Lin, L.-C. The New Storage Technology: Effect of Far Infrared Ray (FIR) Ceramic Sheet Package on Storage Quality of Pork Loin. Asian-Australas. J. Anim. Sci. 2003, 16, 1695–1700. [Google Scholar] [CrossRef]
- Leung, T.; Lin, Y.S.; Lee, C.M.; Chen, Y.C.; Shang, H.F.; Hsiao, S.Y.; Chang, H.T.; Chao, J.S. Direct and Indirect Effects of Ceramic Far Infrared Radiation on the Hydrogen Peroxide-scavenging Capacity and on Murine Macrophages under Oxidative Stress. J. Med. Biol. Eng. 2011, 31, 345–351. [Google Scholar] [CrossRef]










| Method | DSC | TGA | ||||
|---|---|---|---|---|---|---|
| Sample | Tm (°C) | ΔHm (J/g) | Xc (%) | T5% (°C) | T10% (°C) | Residues (%) |
| LDPE/MC-0 | 109.03 | 110.9 | 37.8 | 435.4 | 449.6 | 0.05 |
| LDPE/MC-0.5 | 109.25 | 128.7 | 41.9 | 436.2 | 450.0 | 0.32 |
| LDPE/MC-1 | 109.51 | 135.5 | 43.2 | 432.4 | 446.9 | 0.55 |
| LDPE/MC-3 | 109.79 | 145.6 | 49.7 | 436.9 | 451.0 | 2.50 |
| LDPE/MC-5 | 109.90 | 150.5 | 51.3 | 440.4 | 453.4 | 4.33 |
| Type | E. coli | % R | S. aureus | % R | |
|---|---|---|---|---|---|
| Sample | |||||
| LDPE/MC-0 | ![]() | - | ![]() | - | |
| LDPE/MC-0.5 | ![]() | 90.8 | ![]() | 95.2 | |
| LDPE/MC-1 | ![]() | 81.4 | ![]() | 72 | |
| LDPE/MC-3 | ![]() | 7.3 | ![]() | 52.6 | |
| LDPE/MC-5 | ![]() | 2.6 | ![]() | 30.1 | |
Publisher’s Note: MDPI stays neutral with regard to jurisdictional claims in published maps and institutional affiliations. |
© 2022 by the authors. Licensee MDPI, Basel, Switzerland. This article is an open access article distributed under the terms and conditions of the Creative Commons Attribution (CC BY) license (https://creativecommons.org/licenses/by/4.0/).
Share and Cite
Sakdapipanich, J.; Rodgerd, P.; Sakdapipanich, N. A Low-Density Polyethylene (LDPE)/Macca Carbon Advanced Composite Film with Functional Properties for Packaging Materials. Polymers 2022, 14, 1794. https://doi.org/10.3390/polym14091794
Sakdapipanich J, Rodgerd P, Sakdapipanich N. A Low-Density Polyethylene (LDPE)/Macca Carbon Advanced Composite Film with Functional Properties for Packaging Materials. Polymers. 2022; 14(9):1794. https://doi.org/10.3390/polym14091794
Chicago/Turabian StyleSakdapipanich, Jitladda, Phawasoot Rodgerd, and Natdanai Sakdapipanich. 2022. "A Low-Density Polyethylene (LDPE)/Macca Carbon Advanced Composite Film with Functional Properties for Packaging Materials" Polymers 14, no. 9: 1794. https://doi.org/10.3390/polym14091794
APA StyleSakdapipanich, J., Rodgerd, P., & Sakdapipanich, N. (2022). A Low-Density Polyethylene (LDPE)/Macca Carbon Advanced Composite Film with Functional Properties for Packaging Materials. Polymers, 14(9), 1794. https://doi.org/10.3390/polym14091794